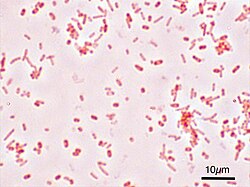

Gastroenteritis (grč. γαστήρ, gaster - želudac, trbuh + έντερο, entero - tanko crijevo, utroba + ῖτις, itis - upala) je patološko stanje koje karakterizira upala probavnog sustava koja obuhvaća i želudac i tanko crijevo, što za posljedicu ima kombinaciju proljeva, povraćanja, te bolove i grčeve u trbuhu.[1] Gastroenteritis se također naziva "crijevna viroza", "pokvareni želudac" i "želučani virus". Iako nije vezan uz gripu, također ga se naziva "želučana gripa" i "crijevna gripa".
Glavni uzročnik gastroenteritisa kod djece u svijetu je rotavirus.[2] Kod odraslih su češći norovirus[3] i Campylobacter.[4] Rjeđi uzroci gastroenteritisa su druge vrste bakterija (ili njihovi toksini) te neki paraziti. Do prijenosa može doći zbog konzumiranja nepravilno pripremljene hrane, zagađene vode ili putem bliskog kontakta sa zaraženim osobama.
Osnovna terapija kod gastroenteritisa je pravilan unos tekućina (hidratacija). U blagim ili umjerenim slučajevima, to se obično postiže oralnom rehidracijskom otopinom, dok je kod težih slučajeva potreban unos intravenoznim putem. Gastroenteritis najviše pogađa djecu i stanovništvo zemalja u razvoju.
Simptomi i znakovi
Gastroenteritis obično uzrokuje proljev i povraćanje,[5] ili se, rjeđe, pojavljuje samo s jednim ili drugim simptomom.[1] Također se mogu pojaviti grčevi u predjelu trbuha.[1] Znakovi i simptomi obično započnu 12–72 sati nakon dolaska u dodir s uzročnikom zaraze.[6] Ako je uzrok zaraze virus, stanje se obično povlači unutar jednog tjedna.[5] Neki virusni uzročnici mogu također izazvati groznicu, zamor, glavobolju i bol u mišićima.[5] Ako se pojavi krvava stolica, manje je vjerojatno da je uzročnik virus[5] i vjerojatnije je da je bakterija ili parazit.[7] Neke bakterijske zaraze mogu biti vezane uz oštru bol u trbuhu i mogu trajati više tjedana.[7]
Djeca zaražena rotavirusom se obično potpuno oporave unutar tri do osam dana.[8] Međutim, u siromašnim državama liječenje težih infekcija često nije dostupno i uobičajeno je da proljev traje vrlo dugo.[9] Dehidracija je česta komplikacija uzrokovana proljevom,[10] i dijete sa znatnim stupnjem dehidracije može imati produljeno vrijeme protoka kapilara, slab turgor kože i otežano disanje.[11] Opetovane zaraze su obično prisutne u područjima sa slabim higijenskim uvjetima, a posljedice mogu biti pothranjenost,[6] usporen rast i razvoj djeteta, a dugoročno i mentalna zaostalost.[12]
Reaktivni artritis se javlja kod 1% osoba nakon zaraze bakterijom Campylobacter, a Guillain-Barréov sindrom se javlja u 0,1% slučajeva.[7] Hemolitičko-uremički sindrom (HUS) se može pojaviti kao komplikacija zaraze vrstama Escherichia coli ili Shigella koje proizvode shiga toksin, dovodeći do niske razine trombocita, bubrežne isuficijencije i hemolitičke anemije.[13] Djeca su podložnija obolijevanju od HUS-a od odraslih osoba.[12] Neke virusne zaraze mogu uzrokovati benigne epizode epilepsije.[1]
Uzroci
Virusi (pogotovo rotavirus) te bakterijske vrste Escherichia coli i Campylobacter su primarni uzročnici gastroenteritisa.[6][14] Postoje, međutim, mnogi drugi uzročnici zaraze koji mogu uzrokovati ovaj sindrom.[12] Povremeno se javljaju neinfektivni uzroci, ali oni su manje vjerojatni od virusne ili bakterijske etiologije.[1] Opasnost od infekcije je veća kod djece zbog njihovog oslabljenog imuniteta i relativno slabe higijene.[1]
Virusi
Virusi za koje je poznato da uzrokuju gastroenteritis su rotavirusi, norovirusi, adenovirusi i astrovirusi.[5][15] Rotavirus je najčešći uzročnik gastroenteritisa kod djece,[14] i ima sličnu učestalost pojave u razvijenim zemljama i u zemljama u razvoju.[8] Virusi uzrokuju približno 70% slučajeva zaraznog proljeva u pedijatrijskoj dobnoj skupini.[16] Rotavirus je rjeđi uzrok kod odraslih zbog stečenog imuniteta.[17]
Norovirus je najčešći uzrok gastroenteritisa među odraslima u razvijenom svijetu i uzrokuje više od 90% slučajeva zaraze.[5] Ove lokalizirane epidemije se obično pojavljuju kada grupe ljudi provode vrijeme u međusobnoj fizičkoj blizini, kao što je slučaj na brodovima za krstarenje,[5] u bolnicama ili u restoranima.[1] Osobe mogu ostati zarazne čak i nakon prestanka proljeva.[5] Norovirus je kao uzročnik puno manje prisutan kod djece, s približno 10% ukupnih slučajeva zaraze.[1]
Bakterije
U razvijenim zemljama, Campylobacter jejuni je primarni uzročnik bakterijskog gastroenteritisa, a polovica tih slučajeva je vezana za doticaj s peradi.[7] Kod djece, bakterije uzrokuju približno 15% slučajeva, a najčešće su vrste Escherichia coli, Salmonella,Shigella, i Campylobacter.[16] Ako se hrana kontaminira bakterijama i ostane na sobnoj temperaturi nekoliko sati, bakterije se razmnažaju i povećavaju opasnost od zaraze za osobe koje istu hranu konzumiraju.[12] Neke vrste hrane koje se obično povezuju s oboljenjem su sirovo ili nedovoljno pečeno meso, piletina, morski plodovi i jaja, sirove klice, nepasterizirano mlijeko i meki sirevi te voćni sokovi i centrifugirani sokovi od povrća.[18] U zemljama u razvoju, posebno u subsaharskoj Africi i Aziji, kolera je čest uzročnik gastroenteritisa. Ovu zarazu uzrokuje bakterija Vibrio Colerae i obično se prenosi kontaminiranom vodom ili hranom.[19]
Toksigena bakterija Clostridium difficile je važan uzročnik proljeva koja se češće javlja kod starijih osoba.[12] Dojenčad može biti prenositelj ove bakterije bez razvijanja simptoma.[12] To je čest uzrok proljeva kod osoba koje su hospitalizirane i često je uzrokovana znatnom uporabom antibiotika.[20] Infektivni proljev uzrokovan vrstom Staphylococcus aureus se također može pojaviti kod osoba koje su koristile antibiotike.[21] Tzv. "putna dijareja" je obično vrsta bakterijskog gastroenteritisa. Čini se da lijekovi za smanjenje želučane kiseline uvelike povećavaju opasnost od zaraze prilikom izlaganja nizu organizama, uključujući vrste Clostridium difficile, Salmonella, i Campylobacter.[22] Opasnost je veća kod osoba koje koriste inhibitore protonske pumpe nego kod H2 blokatora.[22]
Paraziti
Niz praživotinja može uzrokovati gastroenteritis; najčešći je uzročnik Giardia lamblia, ali vrste Entamoeba histolytica i Cryptosporidium također mogu izazvati zarazu.[16] Praživotinje kao grupa čine približno 10% slučajeva gastroenteritisa kod djece.[13] Giardia se češće javlja u razvijenim zemljama, ali ovaj je mikroorganizam raširen u cijelom svijetu.[23] Javlja se češće kod osoba koje su putovale u područja s visokom učestalosti, kod djece koja pohađaju vrtić, kod muškaraca koji imaju homoseksualne odnose i nakon prirodnih katastrofa.[23]
Prijenos
Do prijenosa može doći ako se konzumira onečišćena voda ili ako osobe dijele kontaminirane predmete za osobnu uporabu.[6] U mjestima u kojima se izmjenjuju vlažna i sušna godišnja doba kvaliteta vode obično bude lošija tijekom vlažnog godišnjeg doba, što se u pravilu poklapa s vremenom izbijanja epidemije.[6] U područjima s umjerenom klimom zaraze su učestalije zimi.[12] Hranjenje beba bočicom bez da se bočica primjereno dezinficira značajan je uzrok zaraze u cijelom svijetu.[6] Stopa prijenosa ujedno je povezana s lošom higijenom, naročito kad su u pitanju djeca[5] u prenapučenim kućanstvima[24] i kućanstvima s lošim stanjem po pitanju uhranjenosti.[12] Nakon što se razvije tolerancija, odrasle osobe mogu u sebi nositi određene organizme bez da pokazuju znakove ili simptome bolesti i tako mogu služiti kao prirodni spremnici zaraze.[12] Dok se neki uzročnici (kao što je Shigella) javljaju samo kod primata, ostali se mogu pojaviti kod raznih vrsta životinja (kao što je giardia).[12]
Nezarazni uzroci
Postoji nekoliko nezaraznih uzroka upale probavnog trakta.[1] U neke od učestalijih spadaju lijekovi (kao što su analgetici), određena hrana kao što su laktoza (u osoba koje su netolerantne) i gluten (u osoba koje boluju od celijakije), te Kronova bolest koja je također nezarazan uzrok (često vrlo ozbiljnog) gastroenteritisa.[1] Do gastroenteritisa može doći i unošenjem toksina putem hrane. Primjeri intoksikacije hranom, koja uključuju mučninu, povraćanje i proljev, su: trovanje toksinom ciguatera zbog konzumiranja riba koje su prethodno akumulirale toksin, skombroid koji je povezan s konzumacijom određenih vrsta pokvarene ribe, trovanje tetrodotoksinom koje, između ostalog, nastaje konzumacijom ribe napuhače, te botulizam koji se javlja zbog čuvanja hrane u neprimjerenoj ambalaži.[25]
Patofiziologija
Gastroenteritis se definira kao povraćanje ili proljev koji je posljedica upale tankog ili debelog crijeva.[12] Promjene na tankom crijevu obično nisu upalne, dok na debelom crijevu u pravilu jesu.[12] Patogeni organizmi koji izazivaju upalu mogu biti malobrojni, čak samo jedan (kao u slučaju Cryptosporidiuma), pa sve do 108 (u slučaju Vibrio cholerae).[12]
Dijagnoza
Gastroenteritis se obično dijagnosticira kliničkim pregledom znakova i simptoma koje osoba manifestira.[5] Utvrđivanje točnog uzroka obično nije potrebno jer ta informacija ne mijenja način liječenja.[6] Međutim, pregled kulture stolice mora se izvršiti kod osoba s krvi u stolici, osoba koje su se otrovale hranom i onih osoba koje su nedavno putovale u zemlje u razvoju.[16] Dijagnostičko ispitivanje može se izvršiti radi nadzora nad tijekom bolesti.[5] Budući da se hipoglikemija javlja kod približno 10 % dojenčadi i male djece, za ovu populaciju preporučuje se mjerenje serumske koncentracije glukoze.[11] Elektroliti i funkcija bubrega trebali bi se provjeriti ako postoji bojazan od teške dehidracije.[16]
Dehidracija
Utvrđivanje je li osoba dehidrirala ili nije važan je dio procjene, pri čemu se dehidracija obično dijeli na blagu (3–5 %), umjerenu (6–9 %) i tešku (≥ 10 %).[1] Najtočniji pokazatelji umjerene ili teške dehidracije kod djece su produljeno vrijeme protoka kapilara, oslabljen turgor kože i otežano disanje.[11][26] Ostali korisni pokazatelji (kada su u kombinaciji) su upale oči, smanjena aktivnost, nedostatak suza i suha usta,[1] dok su normalno mokrenje i oralni unos tekućine umirujući pokazatelji, koji ukazuju na normalnu hidrataciju.[11] Laboratorijsko ispitivanje nema bitnu kliničku korist pri utvrđivanju stupnja dehidracije.[1]
Diferencijalna dijagnoza
Ostali mogući uzroci znakova i simptoma, koji oponašaju one uočene kod gastroenteritisa i koji se trebaju isključiti, su upala crvuljka, volvulus, upalna bolest crijeva, upala mokraćnog sustava i dijabetes.[16] Treba se uzeti u obzir i insuficijencija gušterače, sindrom kratkog crijeva, Whippleova bolest, celijakija i zlouporaba laksativa.[27] Diferencijalna dijagnoza može biti donekle komplicirana ako osoba ima samo jedan simptom, npr. samo povraća ili ima proljev (umjesto i jedno i drugo).[1]
Upala crvuljka može se u do 33 % slučajeva manifestirati povraćanjem, bolovima u trbuhu i laganim proljevom,[1] što je u suprotnosti s jakim proljevom koji je uobičajen kod gastroenteritisa.[1] Upala pluća ili mokraćnog sustava kod djece može također dovesti do povraćanja ili proljeva.[1] Klasična dijabetička ketoacidoza manifestira se bolovima u trbuhu, mučninom i povraćanjem, ali bez proljeva.[1] Jedna je studija pokazala da je kod 17 % djece s dijabetičkom ketoacidozom početno dijagnosticiran gastroenteritis.[1]
Prevencija
Način života
Opskrba lako dostupnom pitkom vodom i pravilne higijenske navike važni su preduvjeti u smanjenju stopa zaraze i klinički značajnog gastroenteritisa.[12] Pokazalo se da se primjenom osobnih mjera higijene (poput pranja ruku) smanjuju stope učestalosti i pretežnosti gastroenteritisa za čak 30 % kako u razvijenim zemljama tako i u zemljama u razvoju,[11] a učinkovita može biti i uporaba alkoholnih gelova.[11] Dojenje je vrlo važno, naročito u mjestima s lošom higijenom, kao i opće poboljšanje higijene.[6] Dokazano je da majčino mlijeko smanjuje učestalost zaraza i njihovo trajanje.[1] Učinkovito može biti i izbjegavanje zaražene hrane ili pića.[28]
Cijepljenje
Svjetska zdravstvena organizacija je 2009. preporučila da se, zbog njegove učinkovitosti i sigurnosti, djeca u cijelom svijetu cijepe cjepivom protiv rotavirusa.[14][29] Trenutno postoje dva komercijalna cjepiva protiv rotavirusa, a još nekoliko ih je u fazi razvoja.[29] Ova su cjepiva u Africi i Aziji smanjila pojavu ozbiljnih slučajeva gastroenteritisa kod dojenčadi,[29] a u zemljama u kojima su na snazi državni programi imunizacije uočeno je smanjenje stopa i ozbiljnosti bolesti.[30][31] Ovo cjepivo ujedno može spriječiti oboljenje kod djece koja nisu cijepljena zbog smanjenja broja kružnih zaraza.[32] Primjena programa cijepljenja cjepivom protiv rotavirusa je od 2000. u Sjedinjenim Američkim Državama znatno smanjila broj slučajeva proljeva, za čak 80 posto.[33][34][35] Prva doza cjepiva daje se dojenčetu starom 6 do 15 tjedana.[14] oralno cjepivo protiv kolere pokazalo se učinkovitim u 50-60% slučajeva u razdoblju od 2 godine.[36]
Liječenje
Gastroenteritis je obično akutna i samoograničavajuća bolest koja ne zahtijeva liječenje.[10] Poželjan način liječenja u slučaju blage do umjerene dehidracije je oralna rehidracijska terapija (ORT).[13] Međutim, metoklopramid i/ili ondansetron mogu biti od pomoći kod djece,[37] dok je butilskopolamin koristan kod ublažavanja bolova u trbuhu.[38]
Rehidracija
Rehidracija je primaran način liječenja gastroenteritisa kod djece i odraslih. Ovo se najbolje postiže terapijom oralne rehidracije, iako rehidracija intravenoznim putem može biti potrebna ako je smanjena razina svijesti ili je u pitanju teška dehidracija.[39][40] Oralni nadomjesni terapijski proizvodi sa složenim ugljikohidratima (npr. onima iz pšenice ili riže) mogu biti bolji od onih koji se temelje na jednostavnim šećerima.[41] Pića s posebno velikim udjelom jednostavnih šećera, kao što su bezalkoholna pića i voćni sokovi, ne preporučuju se za djecu ispod 5 godina jer mogu izazvati jači proljev.[10] Može se konzumirati obična voda ako nisu dostupni određeni i učinkoviti preparati za oralnu rehidracijsku terapiju ili ako nisu ukusni.[10] Nazogastrična sonda može se koristiti za unos tekućina kod male djece ako je to opravdano.[16]
Prehrana
Preporuča se da se djeca koja se hrane dojenjem nastave hraniti na uobičajeni način, dok se dojenčad koja se hrani umjetnom formulom nastavi tako hraniti nakon oralne rehidratacijske terapije.[42] Umjetna prehrana bez laktoze ili sa smanjenom količinom laktoze u većini slučajeva nije potrebna.[42] Djeca mogu nastaviti svoj uobičajen način prehrane tijekom epizoda proljeva s izuzetkom hrane bogate jednostavnim šećerima, koju bi trebalo izbjegavati.[42] Tzv. Dijeta BRAT (banana, riža, jabučni sok i čaj) se više ne preporučuje, pošto ne sadrži dovoljno nutrijenata i ne daje bolje rezultate u odnosu na normalnu prehranu.[42] Neki su se probiotici pokazali učinkovitima u skraćenju trajanja bolesti i smanjenju učestalosti epizoda proljeva,[43] a vjerojatno su djelotvorni i u prevenciji i liječenju proljeva izazvanog antibioticima.[44] Proizvodi od fermentiranog mlijeka (kao jogurt) pokazali su sličnu djelotvornost.[45] Dodavanje cinka pokazalo je određenu učinkovitost i u liječenju i prevenciji proljeva kod djece u zemljama u razvoju.[46]
Antiemetici
Antiemetici mogu biti korisni u liječenju povraćanja kod djece. Ondansetron je učinkovit i u pojedinačnoj dozi, smanjujući tako potrebu za intravenoznom hidratacijom, rjeđom hospitalizacijom i smanjenim povraćanjem,[47][48][49] a isto se tako pokazao učinkovitim i metoklopramid.[49] Terapija ondansetronom je međutim povezana s povećanom učestalošću povratka djece u bolnicu.[50] Po kliničkoj procjeni, intravenozni preparat ondansetrona može biti dan pacijentu oralnim putem.[51]Dimenhidrinat, nema bitnog kliničkog učinka na bolest, osim što smanjuje simptom povraćanja.[1]
Antibiotici
Antibiotici se obično ne koriste kod liječenja gastroenteritisa, osim ako su simptomi posebno teški,[52] ako je bakterijski uzročnik izoliran ili ako simptomi ukazuju na specifičnog bakterijskog uzročnika.[53] Pri upotrebi antibiotika, preferira se korištenje makrolida, kao npr. azitromicin, u odnosu na fluorokinolon, pošto je kod ovog zabilježena veća otpornost.[7] Pseudomembranozni kolitis, koji je najčešće uzrokovan uporabom antibiotika, liječi se prekidom upotrebe antibiotika i terapijom metronidazolom ili vankomicinom.[54] Bakterije i praživotinje osjetljive na ovu terapiju su: Shigella[55] Salmonella typhi,[56] i neke vrste Giardie.[23] Kod gastroenteritisa izazvanog Giardiom i Entamoebom histolyticom, preporučuje se terapija tinidazolom, pošto se pokazala učinkovitijom od metronidazola.[23][57] Svjetska zdravstvena organizacija (WHO) preporuča upotrebu antibiotika kod manje djece s krvavim proljevom i vručicom.[1]
Antidijaroici
Kod antidijaroika postoji teorijska iako vrlo mala mogućnost,[27] izazivanja komplikacija, te se one ne preporučuju u sučajevima krvavog proljeva i vručice.[58] Opioidni analog loperamid, se obično koristi za tretman simptoma proljeva.[59] Loperamid nije preporučen kod vrlo male djece, pošto je sposoban proći kroz nedovoljno formiranu krvno moždanu barijeru, i uzrokovati neurotoksičnost. Bizmutov subsalicilat, netopiva koloidna otopina trivalentnog bizmuta i salicilata, može se koristiti kod blažih slučajeva,[27] ali postoji teorijska mogućnost trovanja salicilatom.[1]
Epidemiologija
Procijenuje se da se svake godine u svijetu desi 3 do 5 milijardi slučajeva gastroenteritisa,[13] uglavnom kod djece u zemljama u razvoju.[6] U 2008. je zabilježen 1,3 milijun smrtnih slučajeva kod gastroenteritisa u djece mlađe od pet godina,[60] većina njih u najsiromašnijim zemljama svijeta.[12] Više od 450 000 smrtnih slučajeva kod djece ispod 5 godina su uzrokovani rotavirusom.[61][62]Kolera uzrokuje tri do pet milijuna slučajeva gastroenteritisa godišnje, od kojih 100 000 završava smrću.[19] U zemljama u razvoju djeca mlađa od dvije godine oboljevaju od klinički relevantnog gastroenteritisa i do šest puta godišnje.[12] Broj slučajeva opada u odrasloj dobi zbog jačanja stečenog imuniteta.[5]
U 1980. godini, gastroenteritis svih vrsta uzrokovao je smrt 4,6 milijuna djece, većinom iz zemalja u razvoju.[54] Učestalost smrti je drastično smanjena oko 2000. nakon masovnije primjene oralne rehidratacijske terapije.[63] U SAD-u je gastroenteritis druga zaraza po učestalosti nakon prehlade, te uzrokuje od 200 do 375 milijuna slučajeva akutnog proljeva godišnje,[5][12] od kojih 10 000 završava smrću.[12] Oko 150 do 300 ovih smrtnih slučajeva su djeca mlađa od pet godina.[1]
Povijest
Pojam "gastroenteritis" je prvi put sponenut 1825.[64] U prošlosti se između ostalih koristio pojam „tifoidna groznica“ ili "cholera morbus“. Manje precizni pojmovi koji su se također koristili su "stisak crijeva", "neumjerenost", "tečenje", "kolika", "prigovaranje utrobe", i ostali zastarjeli termini za akutni proljev.[65]
Društvo i kultura
Gastroenteritis je u svijetu poznat po mnogim kolokvijalnim nadimcima. Najpoznatiji je "Montezumina osveta", ali među ostalim i „pupak Delhija“, "la turista" i "sprint stražnjih vrata".[12] Igrao je veliku ulogu u mnogim vojnim kampanjama, a pretpostavlja se da je vezan uz uzrečicu "bez crijeva nema slave".[12]
Gastroenteritis je u SAD-u odgovoran za 3,7 milijuna posjeta liječniku godišnje i 3 milijuna posjeta u Francuskoj.[66] Procjenjuje se da se u Sjedinjenim Američkom Državama trošak u zdravstvu uzrokovan gastroenteritisom penje na 23 milijarde američkih dolara.[67] Crijevne infekcije uzrokovane samo rotavirusom u SAD-u stvaraju trošak od 1 milijardu dolara.[1]
Istraživanje
Trenutno je nekoliko cjepiva protiv uzročnika gastroenteritisa u fazi razvoja. U razvoju je npr. cjepivo protiv Shigelle i enterotoksične Escherichie coli (ETEC), koje se smatraju dvjema najvažnijim bakterijskim uzročnicima gastroenteritisa.[68][69]
Pojava bolesti kod životinja
Gastroenteritis kod pasa i mački je uzrokovan gotovo istim uzročnicima kao kod čovjeka. Najčešći mikroorganizmi uzročnici gastroenteritisa kod životinja jesu: Campylobacter jejuni, Clostridium difficile, Clostridium perfringens i Salmonella.[70] Veliki broj otrovnih biljaka može kod životinja uzrokovati iste simptome.[71] Neki su mikroorganizmi uzročnici vrlo specifični za određene vrste. Coronavirus zaraznog gastroenteritisa (Transmissible gastroenteritis coronavirus - TGEV) pojavljuje se kod svinja i uzrokuje simptome povraćanja, proljeva i dehidriranosti.[72] Pretpostavlja se da su divlje ptice osnovni prijenosnici zaraze na svinje. Ne postoji specifičan lijek protiv ove bolesti.[73] Ovaj se oblik gastroenteritisa ne prenosi na čovjeka.[74]
Literatura
- ↑ 1,00 1,01 1,02 1,03 1,04 1,05 1,06 1,07 1,08 1,09 1,10 1,11 1,12 1,13 1,14 1,15 1,16 1,17 1,18 1,19 1,20 1,21 1,22 1,23 1,24 Singh, Amandeep (srpanj 2010). "Pediatric Emergency Medicine Practice Acute Gastroenteritis — An Update". Emergency Medicine Practice svezak 7 (broj 7). http://www.ebmedicine.net/topics.php?paction=showTopic&topic_id=229
- ↑ Tate JE, Burton AH, Boschi-Pinto C, Steele AD, Duque J, Parashar UD (veljača 2012). "2008 estimate of worldwide rotavirus-associated mortality in children younger than 5 years before the introduction of universal rotavirus vaccination programmes: a systematic review and meta-analysis". The Lancet Infectious Diseases svezak 12 (broj 2): str. 136.–141.. doi:10.1016/S1473-3099(11)70253-5. PMID 22030330
- ↑ Marshall JA, Bruggink LD (travanj 2011). "The dynamics of norovirus outbreak epidemics: recent insights". International Journal of Environmental Research and Public Health svezak 8 (broj 4): str. 1141.–1149.. doi:10.3390/ijerph8041141. PMC 3118882. PMID 21695033. //www.ncbi.nlm.nih.gov/pmc/articles/PMC3118882/
- ↑ Man SM (prosinac 2011). "The clinical importance of emerging Campylobacter species". Nature Reviews. Gastroenterology & Hepatology svezak 8 (broj 12): str. 669.–685.. doi:10.1038/nrgastro.2011.191. PMID 22025030
- ↑ 5,00 5,01 5,02 5,03 5,04 5,05 5,06 5,07 5,08 5,09 5,10 5,11 5,12 Eckardt AJ, Baumgart DC (siječanj 2011). "Viral gastroenteritis in adults". Recent Patents on Anti-infective Drug Discovery svezak 6 (broj 1): str. 54.–63.. PMID 21210762
- ↑ 6,0 6,1 6,2 6,3 6,4 6,5 6,6 6,7 6,8 • Nepoznat parametar:
last
• Nepoznat parametar:first
• Parametarisbnnije dopušten u klasiweb
• Parametarpagenije dopušten u klasiweb
• Parametarlocationnije dopušten u klasiweb
• Parametareditionnije dopušten u klasiweb - ↑ 7,0 7,1 7,2 7,3 7,4 Galanis, E (11. rujan 2007.). "Campylobacter and bacterial gastroenteritis.". CMAJ : Canadian Medical Association svezak 177 (broj 6): str. 570.–571.. doi:10.1503/cmaj.070660. PMC 1963361. PMID 17846438. //www.ncbi.nlm.nih.gov/pmc/articles/PMC1963361/
- ↑ 8,0 8,1 Meloni, A; Locci, D; Frau, G; Masia, G; Nurchi, AM; Coppola, RC (Rujan 2011.). "Epidemiology and prevention of rotavirus infection: an underestimated issue?". The journal of maternal-fetal & neonatal medicine : the official journal of the European Association of Perinatal Medicine, the Federation of Asia and Oceania Perinatal Societies, the International Society of Perinatal Obstetricians svezak 24 dodatak 2: str. 48.–51.. doi:10.3109/14767058.2011.601920. PMID 21749188
- ↑ "Toolkit". DefeatDD. Inačica izvorne stranice arhivirana 27. travanj 2012.. http://www.defeatdd.org/understanding-crisis/advocacy-outreach/toolkits Pristupljeno 3. svibanj 2012.
- ↑ 10,0 10,1 10,2 10,3 "Management of acute diarrhoea and vomiting due to gastoenteritis in children under 5". National Institute of Clinical Excellence. travanj 2009. http://guidance.nice.org.uk/CG84
- ↑ 11,0 11,1 11,2 11,3 11,4 11,5 • Nedostaje obavezni parametar:
url
• Parametarisbnnije dopušten u klasiweb
• Parametarlocationnije dopušten u klasiweb
• Parametarpagesnije dopušten u klasiweb - ↑ 12,00 12,01 12,02 12,03 12,04 12,05 12,06 12,07 12,08 12,09 12,10 12,11 12,12 12,13 12,14 12,15 12,16 12,17 12,18 12,19 Mandell 2010 Chp. 93
- ↑ 13,0 13,1 13,2 13,3 Elliott, EJ (6. siječanj 2007.). "Acute gastroenteritis in children.". BMJ (Clinical research ed.) svezak 334 (broj 7583): str. 35.–40.. doi:10.1136/bmj.39036.406169.80. PMC 1764079. PMID 17204802. //www.ncbi.nlm.nih.gov/pmc/articles/PMC1764079/
- ↑ 14,0 14,1 14,2 14,3 Szajewska, H; Dziechciarz, P (Siječanj 2010.). "Gastrointestinal infections in the pediatric population.". Current opinion in gastroenterology svezak 26 (broj 1): str. 36.–44.. doi:10.1097/MOG.0b013e328333d799. PMID 19887936
- ↑ Dennehy PH (siječanj 2011). "Viral gastroenteritis in children". The Pediatric Infectious Disease Journal svezak 30 (broj 1): str. 63.–64.. doi:10.1097/INF.0b013e3182059102. PMID 21173676
- ↑ 16,0 16,1 16,2 16,3 16,4 16,5 16,6 Webb, A; Starr, M (Travanj 2005.). "Acute gastroenteritis in children.". Australian family physician svezak 34 (broj 4): str. 227.–231.. PMID 15861741
- ↑ Desselberger U, Huppertz HI (siječanj 2011). "Immune responses to rotavirus infection and vaccination and associated correlates of protection". The Journal of Infectious Diseases svezak 203 (broj 2): str. 188.–195.. doi:10.1093/infdis/jiq031. PMC 3071058. PMID 21288818. //www.ncbi.nlm.nih.gov/pmc/articles/PMC3071058/
- ↑ Nyachuba, DG (Svibanj 2010.). "Foodborne illness: is it on the rise?". Nutrition Reviews svezak 68 (broj 5): str. 257.-269.. doi:10.1111/j.1753-4887.2010.00286.x. PMID 20500787
- ↑ 19,0 19,1 Charles, RC; Ryan, ET (Rujan 2011.). "Cholera in the 21st century.". Current opinion in infectious diseases svezak 24 (broj 5): str. 472.-477.. doi:10.1097/QCO.0b013e32834a88af. PMID 21799407
- ↑ Moudgal, V; Sobel, JD (Veljača 2012.). "Clostridium difficile colitis: a review.". Hospital practice (1995) svezak 40 (broj 1): str. 139.-148.. doi:10.3810/hp.2012.02.954. PMID 22406889
- ↑ Lin, Z; Kotler, DP; Schlievert, PM; Sordillo, EM (Svibanj 2010.). "Staphylococcal enterocolitis: forgotten but not gone?". Digestive diseases and sciences svezak 55 (broj 5): str. 1200.-1207.. PMID 19609675
- ↑ 22,0 22,1 Leonard, J; Marshall, JK; Moayyedi, P (Rujan 2007.). "Systematic review of the risk of enteric infection in patients taking acid suppression.". The American journal of gastroenterology svezak 102 (broj 9): str. 2047.–2056.; quiz 2057. doi:10.1111/j.1572-0241.2007.01275.x. PMID 17509031
- ↑ 23,0 23,1 23,2 23,3 Escobedo, AA; Almirall, P; Robertson, LJ; Franco, RM; Hanevik, K; Mørch, K; Cimerman, S (Rujan 2010.). "Giardiasis: the ever-present threat of a neglected disease.". Infectious disorders drug targets svezak 10 (broj 5): str. 329.–348.. PMID 20701575
- ↑ Grimwood, K; Forbes, DA (Prosinac 2009.). "Acute and persistent diarrhea.". Pediatric clinics of North America svezak 56 (broj 6): str. 1343.–1361.. doi:10.1016/j.pcl.2009.09.004. PMID 19962025
- ↑ Lawrence, DT; Dobmeier, SG; Bechtel, LK; Holstege, CP (Svibanj 2007.). "Food poisoning.". Emergency medicine clinics of North America svezak 25 (broj 2): str. 357.-373.; abstract ix. doi:10.1016/j.emc.2007.02.014. PMID 17482025
- ↑ Steiner, MJ; DeWalt, DA; Byerley, JS (9. lipanj 2004.). "Is this child dehydrated?". JAMA : the Journal of the American Medical Association svezak 291 (broj 22): str. 2746.–2754.. doi:10.1001/jama.291.22.2746. PMID 15187057
- ↑ 27,0 27,1 27,2 • Nepoznat parametar:
archiveurl
• Nepoznat parametar:archivedate
• Parametarisbnnije dopušten u klasiweb
• Parametareditornije dopušten u klasiweb
• Parametaraccessdatenije dopušten u klasiweb
• Parametareditionnije dopušten u klasiweb - ↑ "Viral Gastroenteritis". Center for Disease Control and Prevention. veljača 2011. Inačica izvorne stranice arhivirana 24. travanj 2012.. http://www.cdc.gov/ncidod/dvrd/revb/gastro/faq.htm Pristupljeno 16. travanj 2012.
- ↑ 29,0 29,1 29,2 World Health Organization (prosinac 2009). "Rotavirus vaccines: an update". Weekly epidemiological record svezak 51–52 (broj 84): str. 533.–540.. http://www.who.int/wer/2009/wer8451_52.pdf Pristupljeno 10. svibanj 2012.
- ↑ Giaquinto, C; Dominiak-Felden, G; Van Damme, P; Myint, TT; Maldonado, YA; Spoulou, V; Mast, TC; Staat, MA (2011. srpanj). "Summary of effectiveness and impact of rotavirus vaccination with the oral pentavalent rotavirus vaccine: a systematic review of the experience in industrialized countries". Human Vaccines. broj 7 svezak 7: str. 734.–748.. doi:10.4161/hv.7.7.15511. PMID 21734466. http://www.landesbioscience.com/journals/vaccines/article/15511/?nocache=1111012137 Pristupljeno 10. svibanj 2012.
- ↑ Jiang, V; Jiang, B; Tate, J; Parashar, UD; Patel, MM (srpanj 2010). "Performance of rotavirus vaccines in developed and developing countries". Human Vaccines svezak 6 (broj 7): str. 532.–542.. PMID 20622508. http://www.landesbioscience.com/journals/vaccines/article/11278/?nocache=531156378 Pristupljeno 10. svibanj 2012.
- ↑ Patel, MM; Steele, D; Gentsch, JR; Wecker, J; Glass, RI; Parashar, UD (Siječanj 2011.). "Real-world impact of rotavirus vaccination.". The Pediatric Infectious Disease Journal svezak 30 (broj 1 (dodatak)): str. S1.-S5.. doi:10.1097/INF.0b013e3181fefa1f. PMID 21183833
- ↑ US Center for Disease Control and Prevention (2008). "Delayed onset and diminished magnitude of rotavirus activity—United States, November 2007 – May 2008". Morbidity and Mortality Weekly Report svezak 57 (broj 25): str. 697.–700.. http://www.cdc.gov/mmwr/preview/mmwrhtml/mm5725a6.htm Pristupljeno 3. svibanj 2012.
- ↑ "Reduction in rotavirus after vaccine introduction—United States, 2000–2009". MMWR Morb. Mortal. Wkly. Rep. svezak 58 (broj 41): str. 1146.–1149.. rujan 2009. PMID 19847149. http://www.cdc.gov/mmwr/preview/mmwrhtml/mm5841a2.htm
- ↑ Tate, JE; Cortese, MM; Payne, DC; Curns, AT; Yen, C; Esposito, DH; Cortes, JE; Lopman, BA et al. (Siječanj 2011.). "Uptake, impact, and effectiveness of rotavirus vaccination in the United States: review of the first 3 years of postlicensure data.". The Pediatric Infectious Disease Journal svezak 30 (broj 1 (dodatak)): str. S56.-S60.. doi:10.1097/INF.0b013e3181fefdc0. PMID 21183842
- ↑ Sinclair, D; Abba, K; Zaman, K; Qadri, F; Graves, PM (16. ožujak 2011.). "Oral vaccines for preventing cholera.". Cochrane database of systematic reviews (Online) (broj 3): str. CD008603. doi:10.1002/14651858.CD008603.pub2. PMID 21412922
- ↑ Alhashimi D, Al-Hashimi H, Fedorowicz Z (2009). Alhashimi, Dunia. ed. "Antiemetics for reducing vomiting related to acute gastroenteritis in children and adolescents". Cochrane Database Syst Rev (broj 2): str. CD005506. doi:10.1002/14651858.CD005506.pub4. PMID 19370620
- ↑ Tytgat GN (2007). "Hyoscine butylbromide: a review of its use in the treatment of abdominal cramping and pain". Drugs svezak 67 (broj 9): str. 1343.–1357.. PMID 17547475
- ↑ "BestBets: Fluid Treatment of Gastroenteritis in Adults". Inačica izvorne stranice arhivirana 12. veljače 2009.. http://www.bestbets.org/bets/bet.php?id=1039 Pristupljeno 15. studenoga 2012.
- ↑
- ↑ Gregorio GV, Gonzales ML, Dans LF, Martinez EG (2009). Gregorio, Germana V. ed. "Polymer-based oral rehydration solution for treating acute watery diarrhoea". Cochrane Database Syst Rev (broj 2): str. CD006519. doi:10.1002/14651858.CD006519.pub2. PMID 19370638
- ↑ 42,0 42,1 42,2 42,3 King CK, Glass R, Bresee JS, Duggan C (studeni 2003). "Managing acute gastroenteritis among children: oral rehydration, maintenance, and nutritional therapy". MMWR Recomm Rep svezak 52 (broj RR-16): str. 1.–16.. PMID 14627948. http://www.cdc.gov/mmwr/preview/mmwrhtml/rr5216a1.htm
- ↑ Allen SJ, Martinez EG, Gregorio GV, Dans LF (2010). Allen, Stephen J. ed. "Probiotics for treating acute infectious diarrhoea". Cochrane Database Syst Rev svezak 11 (broj 11): str. CD003048.. doi:10.1002/14651858.CD003048.pub3. PMID 21069673
- ↑ Hempel, S; Newberry, SJ; Maher, AR; Wang, Z; Miles, JN; Shanman, R; Johnsen, B; Shekelle, PG (9. srpanj 2012.). "Probiotics for the prevention and treatment of antibiotic-associated diarrhea: a systematic review and meta-analysis.". JAMA : the journal of the American Medical Association svezak 307 (broj 18): str. 1959.-1969.. PMID 22570464
- ↑ Mackway-Jones, Kevin (lipanj 2007). "Does yogurt decrease acute diarrhoeal symptoms in children with acute gastroenteritis?". BestBets. Inačica izvorne stranice arhivirana 17. svibnja 2013.. http://www.bestbets.org/bets/bet.php?id=1000 Pristupljeno 15. studenoga 2012.
- ↑ Telmesani, AM (Svibanj 2010.). "Oral rehydration salts, zinc supplement and rotavirus vaccine in the management of childhood acute diarrhea.". Journal of family and community medicine svezak 17 (broj 2): str. 79.–82.. doi:10.4103/1319-1683.71988. PMC 3045093. PMID 21359029. //www.ncbi.nlm.nih.gov/pmc/articles/PMC3045093/
- ↑ DeCamp LR, Byerley JS, Doshi N, Steiner MJ (rujan 2008). "Use of antiemetic agents in acute gastroenteritis: a systematic review and meta-analysis". Arch Pediatr Adolesc Med svezak 162 (broj 9): str. 858.–865.. doi:10.1001/archpedi.162.9.858. PMID 18762604
- ↑ Mehta S, Goldman RD (2006). "Ondansetron for acute gastroenteritis in children". Can Fam Physician svezak 52 (broj 11): str. 1397.–1398.. PMC 1783696. PMID 17279195. http://www.cfp.ca/cgi/pmidlookup?view=long&pmid=17279195
- ↑ 49,0 49,1 Fedorowicz, Z; Jagannath, VA; Carter, B (7. rujan 2011.). "Antiemetics for reducing vomiting related to acute gastroenteritis in children and adolescents.". Cochrane database of systematic reviews (Online) svezak 9 (9): str. CD005506.. doi:10.1002/14651858.CD005506.pub5. PMID 21901699
- ↑ Sturm JJ, Hirsh DA, Schweickert A, Massey R, Simon HK (svibanj 2010). "Ondansetron use in the pediatric emergency department and effects on hospitalization and return rates: are we masking alternative diagnoses?". Ann Emerg Med svezak 55 (broj 5): str. 415.–422.. doi:10.1016/j.annemergmed.2009.11.011. PMID 20031265
- ↑ "Ondansetron". Lexi-Comp. svibanj 2011. Inačica izvorne stranice arhivirana 6. lipnja 2012.. http://www.merckmanuals.com/professional/print/lexicomp/ondansetron.html Pristupljeno 15. studenoga 2012.
- ↑ Traa BS, Walker CL, Munos M, Black RE (travanj 2010). "Antibiotics for the treatment of dysentery in children". Int J Epidemiol svezak 39 (dodatak 1): str. i70.–i74.. doi:10.1093/ije/dyq024. PMC 2845863. PMID 20348130. //www.ncbi.nlm.nih.gov/pmc/articles/PMC2845863/
- ↑ Grimwood K, Forbes DA (prosinac 2009). "Acute and persistent diarrhea". Pediatr. Clin. North Am. svezak 56 (broj 6): str. 1343.–1361.. doi:10.1016/j.pcl.2009.09.004. PMID 19962025
- ↑ 54,0 54,1 • Nepoznat parametar:
url-status
• Nepoznat parametar:last2
• Nepoznat parametar:archive-date
• Nepoznat parametar:last3
• Nepoznat parametar:last1
• Nepoznat parametar:first2
• Nepoznat parametar:first1
• Nepoznat parametar:archive-url
• Nepoznat parametar:first3
• Parametarisbnnije dopušten u klasiweb
• Parametareditionnije dopušten u klasiweb - ↑ Christopher, PR; David, KV; John, SM; Sankarapandian, V (4. kolovoz 2010.). "Antibiotic therapy for Shigella dysentery.". Cochrane database of systematic reviews (Online) (broj 8): str. CD006784.. doi:10.1002/14651858.CD006784.pub4. PMID 20687081
- ↑ Effa, EE; Lassi, ZS; Critchley, JA; Garner, P; Sinclair, D; Olliaro, PL; Bhutta, ZA (5. rujan 2011.). "Fluoroquinolones for treating typhoid and paratyphoid fever (enteric fever).". Cochrane database of systematic reviews (Online) (broj 10): str. CD004530. doi:10.1002/14651858.CD004530.pub4. PMID 21975746
- ↑ Gonzales, ML; Dans, LF; Martinez, EG (15. travanj 2009.). "Antiamoebic drugs for treating amoebic colitis.". Cochrane database of systematic reviews (Online) (broj 2): str. CD006085.. doi:10.1002/14651858.CD006085.pub2. PMID 19370624
- ↑ • Nepoznat parametar:
archivedate
• Nepoznat parametar:archiveurl
• Parametaraccessdatenije dopušten u klasiweb
• Parametarisbnnije dopušten u klasiweb
• Parametareditionnije dopušten u klasiweb - ↑ • Nepoznat parametar:
last3
• Nepoznat parametar:last1
• Nepoznat parametar:first2
• Nepoznat parametar:first1
• Nepoznat parametar:last2
• Nepoznat parametar:first3
• Parametarisbnnije dopušten u klasiweb
• Parametareditionnije dopušten u klasiweb - ↑ Black, RE; Cousens, S; Johnson, HL; Lawn, JE; Rudan, I; Bassani, DG; Jha, P; Campbell, H et al. (5. lipanj 2010.). "Global, regional, and national causes of child mortality in 2008: a systematic analysis.". Lancet svezak 375 (broj 9730): str. 1969.–1987.. doi:10.1016/S0140-6736(10)60549-1. PMID 20466419
- ↑ Tate, JE; Burton, AH; Boschi-Pinto, C; Steele, AD; Duque, J; Parashar, UD (Veljača 2012.). "2008 estimate of worldwide rotavirus-associated mortality in children younger than 5 years before the introduction of universal rotavirus vaccination programmes: a systematic review and meta-analysis.". The Lancet infectious diseases svezak 12 (broj 2): str. 136.–141.. doi:10.1016/S1473-3099(11)70253-5. PMID 22030330
- ↑ World Health Organization (studeni 2008). "Global networks for surveillance of rotavirus gastroenteritis, 2001–2008". Weekly Epidemiological Record svezak 47 (broj 83): str. 421.–428.. http://www.who.int/wer/2008/wer8347.pdf Pristupljeno 10. svibanj 2012.
- ↑ Victora CG, Bryce J, Fontaine O, Monasch R (2000). "Reducing deaths from diarrhoea through oral rehydration therapy". Bull. World Health Organ. svezak 78 (broj 10): str. 1246.–1255.. PMC 2560623. PMID 11100619. //www.ncbi.nlm.nih.gov/pmc/articles/PMC2560623/
- ↑ "Gastroenteritis". Oxford English Dictionary 2011.. http://www.oed.com/ Pristupljeno 15. siječanj 2012.
- ↑ Rudy's List of Archaic Medical Terms. Inačica izvorne stranice arhivirana 9. srpnja 2007.. http://www.antiquusmorbus.com/English/English.htm Pristupljeno 15. studenoga 2012.
- ↑ Flahault, A; Hanslik, T (Studeni 2010.). "[Epidemiology of viral gastroenteritis in France and Europe].". Bulletin de l'Academie nationale de medecine svezak 194 (broj 8): str. 1415.–1424.; discussion 1424.-1425.. PMID 22046706
- ↑ • Nepoznat parametar:
last
• Nepoznat parametar:first
• Parametarisbnnije dopušten u klasiweb
• Parametarlocationnije dopušten u klasiweb
• Parametarpagesnije dopušten u klasiweb - ↑ World Health Organization. "Enterotoxigenic Escherichia coli (ETEC)". Diarrhoeal Diseases. Inačica izvorne stranice arhivirana 15. svibnja 2012.. http://www.who.int/vaccine_research/diseases/diarrhoeal/en/index4.html Pristupljeno 3. svibanj 2012.
- ↑ World Health Organization. "Shigellosis". Diarrhoeal Diseases. http://www.who.int/vaccine_research/diseases/diarrhoeal/en/index6.html Pristupljeno 3. svibanj 2012.
- ↑ Weese, JS (Ožujak 2011.). "Bacterial enteritis in dogs and cats: diagnosis, therapy, and zoonotic potential.". The Veterinary clinics of North America. Small animal practice svezak 41 (broj 2): str. 287.-309.. doi:10.1016/j.cvsm.2010.12.005. PMID 21486637
- ↑ • Nepoznat parametar:
last
• Nepoznat parametar:first
• Parametarisbnnije dopušten u klasiweb
• Parametarlocationnije dopušten u klasiweb
• Parametarpagesnije dopušten u klasiweb
• Parametareditionnije dopušten u klasiweb - ↑ • Nepoznat parametar:
last1
• Nepoznat parametar:first2
• Nepoznat parametar:last2
• Nepoznat parametar:first1
• Parametarisbnnije dopušten u klasiweb
• Parametarpagenije dopušten u klasiweb
• Parametarlocationnije dopušten u klasiweb
• Parametareditionnije dopušten u klasiweb - ↑ • Nepoznat parametar:
last
• Nepoznat parametar:first
• Parametarisbnnije dopušten u klasiweb
• Parametarlocationnije dopušten u klasiweb
• Parametarpagesnije dopušten u klasiweb
• Parametareditionnije dopušten u klasiweb - ↑ • Nepoznat parametar:
last
• Nepoznat parametar:first
• Parametarisbnnije dopušten u klasiweb
• Parametarlocationnije dopušten u klasiweb
• Parametarpagesnije dopušten u klasiweb
• Parametareditionnije dopušten u klasiweb
| Datoteka:Esculaap4.svg | Molimo pročitajte upozorenje o korištenju medicinskih informacija. Ne provodite liječenje bez konzultiranja liječnika! |